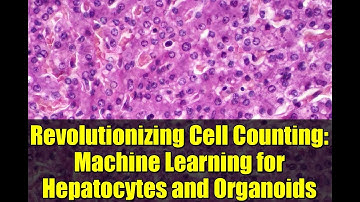
Revolutionizing Cell Counting: Machine Learning for Hepatocytes and Organoids

⬇ DOWNLOAD NOW
Kalau muncul iklan pop-up, tutup lalu klik tombol kembali
Download lagu Webinar | Automated Organoid Counting with the DeNovix CellDrop Automated Cell Counter secara gratis hanya untuk keperluan promosi. Dukung artis favorit kamu dengan membeli musik original di iTunes atau platform resmi lainnya.
 CellDrop Organoids App | Live Demo
CellDrop Organoids App | Live Demo
 CellDrop Automated Cell Counter | Count Cells Without Slides
CellDrop Automated Cell Counter | Count Cells Without Slides
 Denovix: CellDrop™ Cell Counters - „Count Cells Without Slides“
Denovix: CellDrop™ Cell Counters - „Count Cells Without Slides“
 Machine Learning Cell Counting: Hepatocytes & Organoids Revolutionized
Machine Learning Cell Counting: Hepatocytes & Organoids Revolutionized
 CellDrop Hepatocytes App | Live Demo
CellDrop Hepatocytes App | Live Demo
 The Future of Cell Counting: Machine Learning Revolutionizes Hepatocyte and Organoid Analysis
The Future of Cell Counting: Machine Learning Revolutionizes Hepatocyte and Organoid Analysis
Revolutionizing Cell Counting: Machine Learning for Hepatocytes and Organoids
Revolutionizing Cell Counting: Machine Learning for Hepatocytes and Organoids
 Organoid Counting Software for Corning® Cell Counter
Organoid Counting Software for Corning® Cell Counter